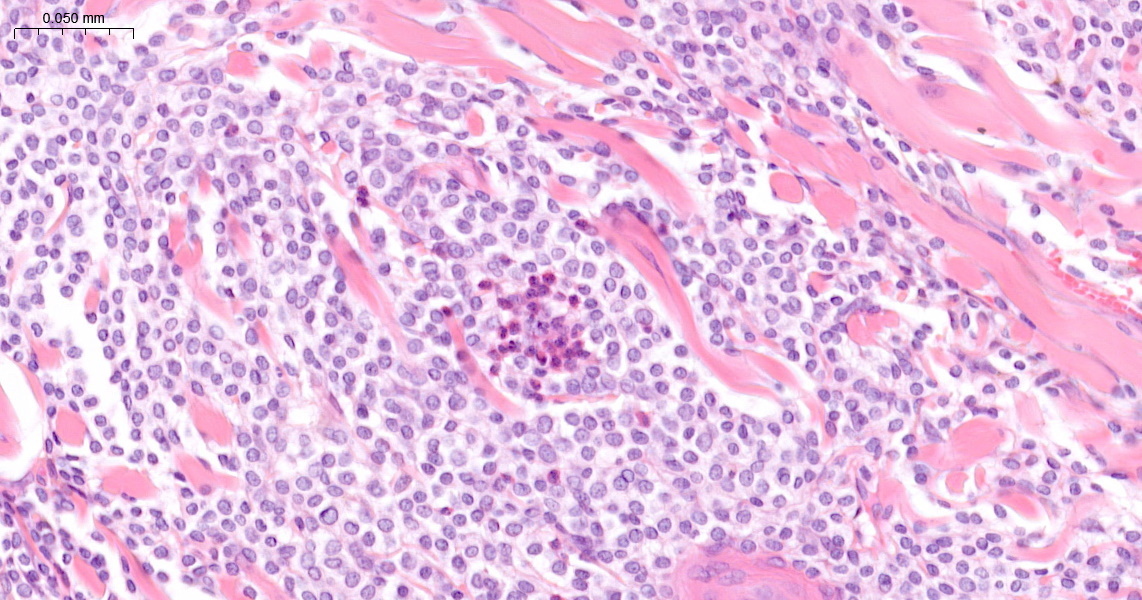
feature-img

Cutaneous mast cell tumours are very common in dogs, often presenting a diagnostic dilemma, with many tumours showing aggressive biological behaviours. Cutaneous mast cell tumours are less common in cats; however, when they do present, they most commonly exhibit benign biological behaviour, so complete excision of the mass is usually curative. Cutaneous mast cell tumours have been reported in several other species as diverse as horses and tortoises. But did you know that cutaneous mast cell tumours are one of the most common skin tumours in domestic ferrets (Mustela putorius furo)?

The case
One particular case concerned a six-year-old male ferret. The lesion was a 10mm diameter raised ulcerated mass from the dorsum (Figure 1).
The mass was densely cellular, with tightly packed uniform round cells showing fine, pale intracytoplasmic granules. Occasional eosinophils were intermixed within scant stroma (Figure 2). There was no nuclear atypia, and mitotic activity was low, typically zero to two mitoses per high-power field (x400). The mass was not encapsulated but had been completely excised together with the underlying panniculus muscle.
The lesion was diagnosed as a cutaneous mast cell tumour based on the lesion’s architecture and cytological features.
This clinical presentation of ulcerated dermal nodules was typical. Lesions tend to be plaque-like and erythematous; they may wax and wane, often looking like they are healing before recurring, and many become ulcerated.
There is no histopathological prognostic grading system for these tumours as the majority are benign, with simple excision being curative. This makes the biological behaviour of cutaneous mast cell tumours in ferrets similar to feline mast cell tumours rather than those found in canines.
As in cats, cutaneous mast cell tumours in ferrets often stain poorly for granules in histological sections. Cytology aspirates stained with toluidine blue or Wright-Giemsa stains tend to stain positively for mast cell granules, which can help rule out other cutaneous round cell tumours.
When considering immunohistochemistry, cutaneous mast cell tumours from ferrets exhibit KIT labelling.
References (click to expand)
| Santoro, M., Stacy, B. A., Morales, J. A., Gastezzi-Arias, P., Landazuli, S. and Jacobson, E. R. | 2008 | Mast cell tumour in a giant Galapagos tortoise (Geochelone nigra vicina). Journal of Comparative Pathology, 138, 156-159 |
| Vilalta, L., Meléndez-Lazo, A., Doria, G., Ramis, A., Solano-Gallego, L., Pastor, J. and Martorell, J. | 2016 | Clinical, cytological, histological and immunohistochemical features of cutaneous mast cell tumours in ferrets (Mustela putorius furo). Journal of Comparative Pathology, 155, 346-355 |






